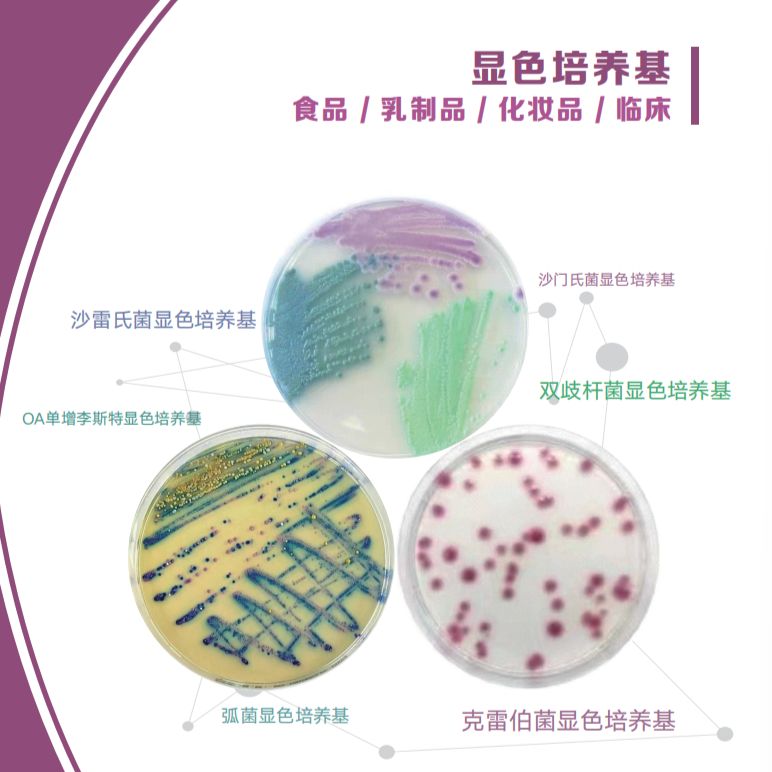
印度HiMedia品牌脱水培养基-生物制药业、显色培养基、药敏纸片、微生物鉴定试剂盒-3

搜索到 84 条记录

Talaromyces rugulosusTalaromyces rugulosus
D62179拉丁名 Talaromyces rugulosus具体用途 其他编号 模式菌株 非模式菌株主要用途 生物危害程度 四类培养基名称 麦芽汁琼脂培养基成分 12 Brix. 麦芽汁 1.0 L琼脂 15.0 g自然pH培养温度 25℃需氧类型 保存方法 冷藏4-10℃提供
品牌:诺安基因货号:RN-89077

三层包装无菌平板培养基(沉降皿、接触皿) 生产环境检测系列
环凯牌三层包装接触皿及沉降皿是环凯公司精心设计、研发推出的制药及食品行业环境无菌监测产品。用于生产环境沉降及表面微生物监测,该系列产品采用了环凯配制的优质干粉培养基原料,引进美国先进生产线生产,配于精心设计的包装,解决了药厂在使用过程遇到的实际问题。 环凯三层包装平板采用A级环境
品牌:HKM/环凯货号:CP成品系列

成品预装培养基平皿(R2A)
成品预装培养基平皿Ø90mm MC841090KR2A琼脂培养基是琼脂平板的一种,适用于纯化水,注射用水微生物的测试,广泛用于制药、食品以及化妆品等企业的环境细菌检测,无菌包装,一次性使用,更方便、安全、卫生。(射线辐照、三层包装,确保无菌,用于洁净环境中细菌分离、培养、计数和鉴
品牌:四季青货号:MS841090K

Pseudalert绿脓假单胞菌检测试剂盒
Pseudalert-24小时检测瓶装水/游泳池水/spa水中的绿脓假单胞菌 Pseudalert绿脓假单胞菌试剂主要用来检测瓶装水、游泳池水以及温泉浴场水样中的绿脓假单胞菌。 该检测基于一种细菌酶检测技术,即绿脓假单胞菌分解代谢 Pseudalert 试剂产生一定的信号,从而证
品牌:IDEXX Laboratories货号:WPSE200I

BJ5183大肠杆菌,Escherichia coli BJ5183,SHBCC D24963,BJ5183
菌种名:BJ5183大肠杆菌 拉丁名:Escherichia coli BJ5183 菌种编号:SHBCC D24963 其他编号:BJ5183 模式菌株:非模式菌株 主要用途:科研 具体用途:具有较高重组活力的菌株,是目前腺病毒系统*常用的感受态细胞 生物危害程度:四类 培养基
品牌:上海保藏生物技术中心SHBCC货号:SHBCC D24963

湖南假单胞菌
中文名称:湖南假单胞菌 拉丁名称:Pseudomonas hunanensis 来源历史:←湖南科技大学 收藏时间:2012/11/2 原始编号:LV 原产国:中国 模式菌株:模式菌株 主要用途:分类;研究 特征特性:革兰氏阴性,短杆菌,具鞭毛;(G+C)mol%=68.8%;16
品牌:百欧博伟货号:bio-56846

双料乳糖蛋白胨培养液(含小倒管)
用途:用于大肠菌群、大肠杆菌的测定。 检验原理:蛋白胨、牛肉浸膏提供碳氮源及矿物质;乳糖是可发酵的糖类;氯化钠维持均衡的渗透压;溴甲//酚紫为pH指示剂,酸性呈黄色,碱性呈紫色。 小倒管排气操作视频链接:http://www.hopebiol.com/video/hbtube.a
品牌:青岛海博生物货号:HBPT009-1

日本三菱厌氧密封罐厌氧产气袋微需氧产气袋
名称:日本三菱厌氧密封罐厌氧产气袋微需氧产气袋 产品简介: 三菱瓦斯化学株式会社(MITSUBISHI GAS CHEMICAL COMPANY, INC.)长期致力于脱氧剂研究,在世界上率先开发出最简便、最经济的厌氧培养系列产品,广泛适用于医院临床检验、食品卫生检疫、啤酒检测监
品牌:三菱货号:C-01
询价

ZeptoMetrix安全无感染的热灭活CFHI病毒培养物-艾滋病毒HIV病毒
ZeptoMetrix® 致力于帮助您的实验室满足各项基于病毒学的检测需求; 我们提供广泛的热灭活形式的病毒培养物,用于科研和检测产品的设计及验证。•简便:每支 1 毫升标准装量,提供灭活前滴度检测数据•多用:可用于检测限(LOD)、交叉反应、包容性、样本稳定性和干扰测试等多项实验
品牌:ZeptoMetrix货号:0810028CFHI等

美久津磷酸盐缓冲液(PBS) 500ml
PBS(phosphate buffered solution)即磷酸盐缓冲液,能够提供相对稳定的离子环境和pH 缓冲能力,是生物学中经常使用的缓冲盐溶液,与人体血液等渗,可用于分子克隆及细胞培养等。主要成分为磷酸二氢钾、氯化钠等,pH 为 7.0-7.2。本产品为 1×工作液,经
品牌:美久津货号:M10101
¥35
印度HiMedia品牌脱水培养基-生物制药业、显色培养基、药敏纸片、微生物鉴定试剂盒-3
印度HiMedia品牌 印度HiMedia脱水培养基-生物制药业 显色培养基-3 序号 品牌 货号 英文名称 中文名称 规格 单位 数量 货期 产品描述 11 HiMedia M011-500G Soyabean Casein Digest Medium(Tryptone Soya
品牌:印度HiMedia品牌脱水培养基-生物制药业、显色培养基-3货号:印度HiMedia品牌脱水培养基-生物制药业、显色培养基-3

菌落总数测试片
菌落总数测试片 大肠杆菌大肠菌群测试片(ECC) 24片/包 食品大肠菌群检测纸片 2份/包 水质大肠菌群检测纸片 1份/包 餐饮具用大肠群检测纸片 100份/20包/盒 大肠埃希氏菌和耐热大肠菌群测试片 24片/包 食品中大肠菌群检测试剂盒(9管法) 10份/盒 水中大肠菌群检
品牌:益货号:24T

MRS培养基 MRS琼脂 MRS琼脂培养基
有效期 1年 级别 BR 别名 MRS琼脂 MRS琼脂培养基 英文名称 MRS Agar 储存条件 RT 单位 瓶 用途:用于食品中乳酸菌的分离培养或计数。 成分(g/L) 蛋白胨 10.0 牛肉浸粉 8.0 酵母浸粉 4.0 葡萄糖 20.0 磷酸氢二钾 2.0 柠檬酸氢二铵
品牌:Solarbio货号:M8330

OXOID胰蛋白胨,OXOID Tryptone
品名 货号 品牌 规格 报价 折后价 胰蛋白胨 LP0042 OXIOD 500g ¥320 ¥260 蛋白胨 编号: LP0042 蛋白胨是酪蛋白的胰消化。它可用于在任何地方指定胰腺或胰蛋白酶消化酪蛋白的配方。酪蛋白是牛奶的主要蛋白质是氨基酸态氮的丰富来源。剖面显示整个分子量范
品牌:OXOID货号:LP0042
询价

Eugon LT 100 琼脂基础
本公司提供质粒培养和原核自动诱导表达的Eugon LT 100 琼脂基础。在相同的条件下,使用质粒培养的Eugon LT 100 琼脂基础,提取质粒DNA得率通常是等体积LB培养基的3-7倍,适合各种高、低拷贝质粒的提取。 该培养基诱导过程自动,诱导条件温和,有助于提高细胞密度、
品牌: Merck货号: hz-M0065B
询价

20%葡萄糖溶液,50X (Ames试验) 毒理实验 AMES细菌回复突变试验 CA染色体畸变试验 基因突变试验
的场所,所以常从肝匀浆中制取S9。20%葡萄糖溶液,50X (Ames试验) 产品介绍:本品为澄清溶液。使用方法:拆封后可直接使用。保存条件:冰袋运输,顺丰快递,2-8℃长期保存。注意事项:在使用过程中要特别注意避免平板内容物污染。本产品仅限于专业人员的科学研究用,不得用于临床诊断
品牌:CHI Scientific货号:6-2210
¥60-120

RS琼脂平板
产品名称:RS琼脂平板产品规格:90mm*20块/盒产品货号:ZC-Medium-18产品用途:用于气单胞菌的分离培养,GB/T 18652-2002 致病性嗜水气单胞菌检验方法
品牌:中创汇科货号:ZC-Medium-18

75mm玫瑰红钠琼脂培养基 等浮游菌检测系列【厂家优惠直销】
【商品名称】 75mm玫瑰红钠琼脂培 养基等一次性成品培养基系列南京便诊公司 【规格编号】 本品的所有规格及对应的我司系统编号; 商品编号 商品名称 规格 供应商 BZW12002 营养琼脂(NAP)[肉汤琼脂平板][空气平皿] 75mm 南京便诊 BZW12113 胰蛋白胨大豆
品牌:南京便诊货号:BZW15205
询价

Cytiva Cytodex 3 microcarriers (dry powder) 17048501
Cytodex3微载体是一款优质、可靠的细胞培养基质,适用于多种细胞类型的培养,如CHO、HEK-293、NS0和PC12等。Cytodex3微载体的独特形状和结构,并可提高细胞生长和繁殖效率。由于其高度稳定、化学惰性和聚合物材料质地,Cytodex3微载体在细胞培养领域受到广泛
品牌:Cytiva货号:17048501
询价








